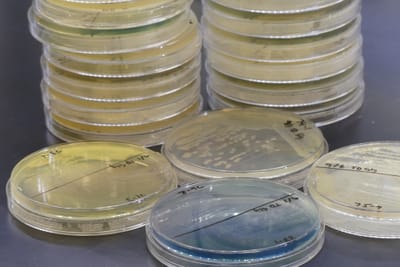
Volatile biomarkers of infection phenotypes

Research Projects
Breath testing solves a major problem with the standard diagnostics for lung infections - access to the infection site.
Read MoreBreath tests can tell us about clinically-important infection phenotypes, such as antibiotic resistance profiles.
Read MoreThe application of comprehensive two-dimensional gas chromatography (GCxGC) to microbial volatile metabolomes has revealed stunning chemical diversity.
Read MoreAre there breath biomarkers that can diagnose different types of fatigue? We're working to find out.
Read MoreMicrobes can smell each other and change their behavior based on which collaborators or competitors they sense in their environment.
Read MoreWe use advanced chromatography and mass spectrometry tools to collect chemical data, and statistical tools to turn the data into information. And when the tools we need aren't available, we develop them.
Read More